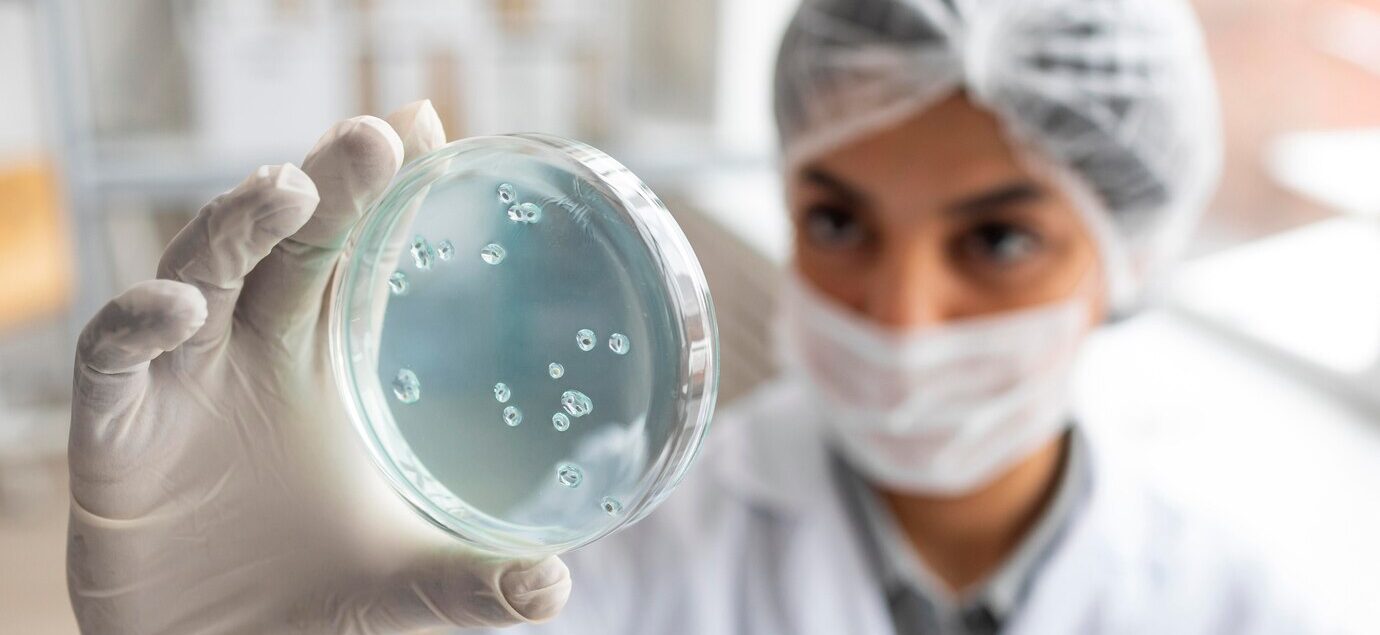

Em que consiste o congelamento de óvulos?
A técnica de congelamento de óvulos, também chamada de vitrificação de oócitos, é um método usado para manter a capacidade reprodutiva da mulher. Com ele, a mulher pode postergar a gravidez sem que isso afete a qualidade de seus óvulos, tendo mais liberdade para planejar a gestação no futuro.
Qual a razão para congelar óvulos?
A capacidade de uma mulher engravidar está ligada à idade, já que, com o tempo, a quantidade e a qualidade dos óvulos diminuem. Isso pode levar a mais casos de infertilidade, abortos e problemas de formação no bebê, além de síndromes genéticas.
Ao escolher o congelamento, a mulher pode decidir quando é o melhor momento para engravidar, mantendo a qualidade dos óvulos coletados na idade em que foram congelados, sem importar a idade que terá na hora da gravidez.
Como se dá o processo de congelamento de óvulos?
O congelamento de óvulos é uma forma de criopreservação que envolve o resfriamento muito rápido dos óvulos até temperaturas bem baixas (-196°C) em nitrogênio líquido.
O processo tem estas etapas:
- Estímulo ovariano
uso de hormônios para estimular a produção de vários óvulos. - Coleta dos óvulos
feita com uma punção no ovário guiada por ultrassom. - Análise dos óvulos
apenas os óvulos maduros (fase de metáfase II – MII) são escolhidos para o congelamento. - Vitrificação
os óvulos passam por um processo de congelamento ultrarrápido com substâncias crioprotetoras para evitar a formação de cristais de gelo. - Armazenamento
os óvulos são guardados em tanques de nitrogênio líquido, onde podem ficar por tempo indeterminado, mantendo sua viabilidade e qualidade.
Quando a mulher decide engravidar, os óvulos são descongelados e fertilizados em laboratório por meio da Fertilização In Vitro (FIV).
Congelamento de óvulos em pacientes com câncer
Pacientes com câncer podem ter problemas de fertilidade devido a tratamentos como quimioterapia, radioterapia ou cirurgias que afetam o funcionamento dos ovários. Congelar os óvulos antes do tratamento do câncer permite que a gravidez seja adiada sem prejudicar a capacidade de ter filhos.
Ao guardar os óvulos antes da terapia contra o câncer, a mulher mantém a chance de ter filhos no futuro, com as mesmas chances que teria no momento do diagnóstico. Para isso, é importante procurar um médico assim que souber da doença, para que o congelamento seja feito antes do tratamento, sem afetar sua eficácia.
O que avaliar antes de congelar os óvulos?
É preciso analisar alguns pontos antes de optar pelo congelamento de óvulos, como:
- Idade da paciente e quantos óvulos ela ainda tem.
- Tempo disponível antes de começar o tratamento do câncer.
- Permissão do médico oncologista para fazer o procedimento.
O número de óvulos congelados impacta de forma significativa as perspectivas de uma futura gravidez bem-sucedida. Depois da coleta e com a autorização do médico, a mulher poderá buscar a gravidez através de métodos de Reprodução Assistida, por exemplo, a Fertilização In Vitro (FIV).